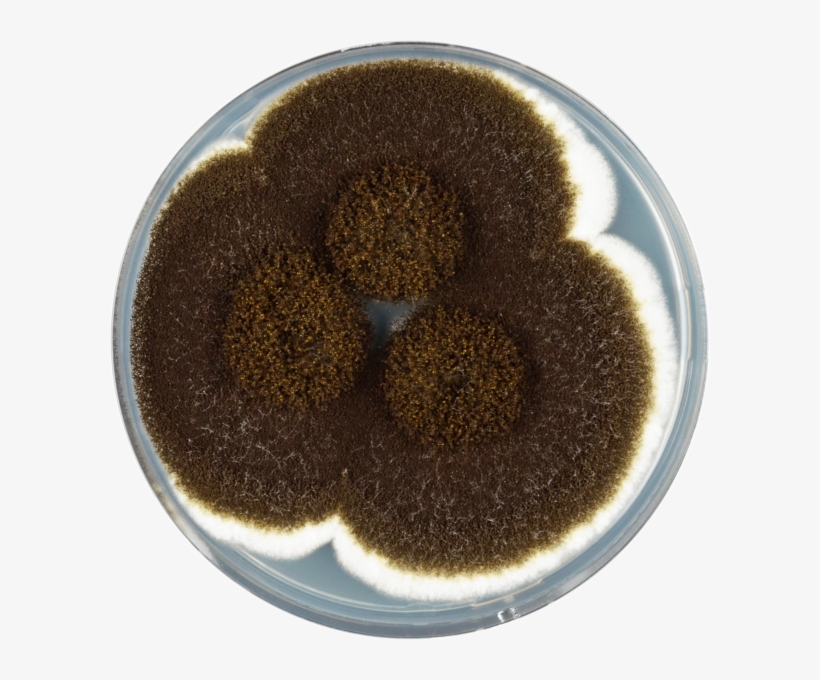
Aspergillus Heteromorphus Cya - Aspergillus, transparent png download

This Aspergillus Heteromorphus Cya - Aspergillus is high quality PNG picture material, which can be used for your creative projects or simply as a decoration for your design & website content. Aspergillus Heteromorphus Cya - Aspergillus is a totally free PNG image with transparent background and its resolution is 600x600. You can always download and modify the image size according to your needs. NicePNG also collects a large amount of related image material, such as null.
| Image type: | PNG |
|---|---|
| Resolution: | 600x600 |
| Name | Aspergillus Heteromorphus Cya - Aspergillus |
| License: | Personal Use |
| Size | 634 KB |
| Views | 16 |
| Downloads | 3 |